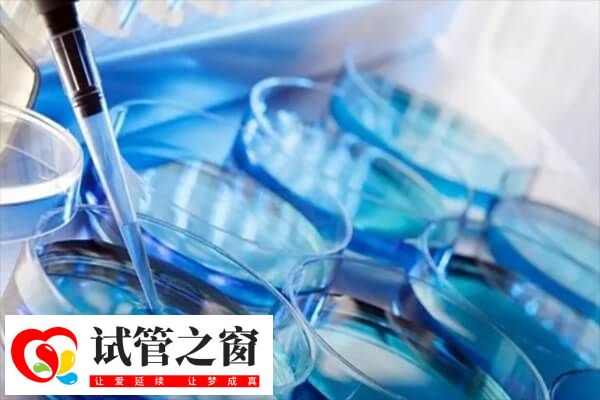
染色體平衡異位做三代試管怎么樣(圖1) 染色體平衡易位是一種常見的遺傳疾病

染色體平衡異位做三代試管怎么樣
染色體平衡異位患者,做三代試管的成功率通常較高,這是因為這項技術可以在胚胎植入前對其進行遺傳學檢測,篩選出健康的胚胎進行移植,從而提高生育成功率。此外,有了解到染色體平衡易位患者做三代試管的成功概率相對較高,通常在50%-60%,不過具體還要以實際為準。
染色體平衡異位做三代試管的優勢
染色體平衡易位是一種常見的遺傳疾病,可以導致患者在生殖過程中面臨困擾。不過對于存在這類情況的患者,可以選擇三代試管嬰兒助孕,這時還具有以下幾點優勢。
1、?提高受孕成功率
三代試管技術是一種通過篩選胚胎來減少遺傳疾病傳遞的方法。在染色體平衡易位患者中,PGT可以有效提高受孕成功率。
2、選擇優勢胚胎
通過輔助生殖技術(如體外受精),醫生可以獲取多個胚胎。然后,在胚胎發育到一定階段時,取一小部分細胞進行遺傳學檢測,排除異位的胚胎進行移植。
3、降低遺傳疾病風險
染色體平衡異位做三代試管時,這些細胞中的DNA將被分析,以確定是否存在染色體平衡易位及其相關的基因異常。在檢測結果可行的情況下,只有正常染色體和基因組合的胚胎會被選擇用于植入子宮。這種篩選過程大大提高了成功率,并降低了出現遺傳疾病的風險。?
染色體平衡異位做三代試管的成功率
染色體平衡易位患者通過三代試管技術可以達到50%的受孕成功率。這一突破性成果得益于三代試管技術對胚胎進行基因篩選的能力,從而降低了遺傳疾病的風險。隨著技術的進一步發展,這項技術將為染色體平衡易位患者帶來更多希望和機遇。

雖然三代試管技術可以顯著提高染色體易位患者的生育成功率,但并不能保證100%的成功。患者在接受治療前應充分了解相關風險和注意事項,并在醫生的指導下進行決策和治療。





